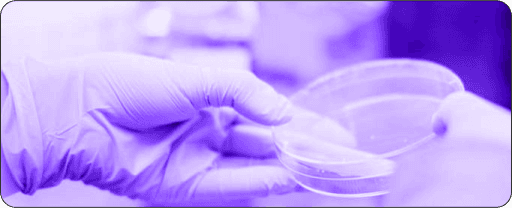
Helping the advancement of research

Helping Global Teams Build Learning Culture Since 2008
SkillsDB is the skills intelligence platform behind some of the world's most capable workforces — connecting skills data to the decisions that grow people and organizations.




Trusted by some of the world's best companies
Make learning culture universal
Our mission is to make learning culture universal, helping L&D teams realize the full potential of the people they serve.
Winning organizations align their mission with the growth of their employees. We call this career clarity.
We're building a future where career clarity is the norm. Where people can rise to any level through diligent skill and competency development.
Many of the most notable global organizations, including those in the Fortune 500, have relied on SkillsDB for their learning programs. And we're just getting started.
We're a global team, with global customers
SkillsDB is the platform for organizations across industries, languages, cultures, and geographies worldwide. Our values guide everything we do.
Deliver learning culture, not software
We don't build software; we help customers deliver learning culture and build winning teams. Look past the product.
Our customer's goal is our goal; our product is just one tool for achieving it.
We take direct responsibility for the outcomes our customers need from their learning programs — for their workflows, the success of their end users, and the end results.
Be hyper-responsive
Our customers are accountable to entire organizations. When they need something from us, we respond with extreme urgency.
Each of us represents the company.
Stay focused, apply yourself, and get the result.
Become indispensable
Find the 'need behind the need,' and do everything you can to support it. Treat our customers and users like colleagues.
Your job description is 'be useful, period.'
Be reliable and predictable. Be the person who delivers, regardless of the context. Play to win. There is no room to be passive.
Never 'wait and see.' Be highly adaptable.
Keep tight tolerances
Speed of execution and quality output begin with precision. Working with precision means proactively owning the details.
Focus on simplicity with every pixel, line of code, word or action. Remove everything unnecessary.
Anticipate your audience; their needs, questions, and concerns. Anticipate what can go wrong and get ahead of it.
Love what you make
Life is too short to build something you don't believe in.
Craft comes from deeply considering users and their ultimate needs, and then delivering however possible.
We can always learn more about how our users think and feel and what's important to them. Always remember to ask why.
Curiosity is key to craft.
Our Perspective
Founded in 2008, SkillsDB has spent years helping organizations turn skills data into workforce strategy. Read how our thinking has evolved.